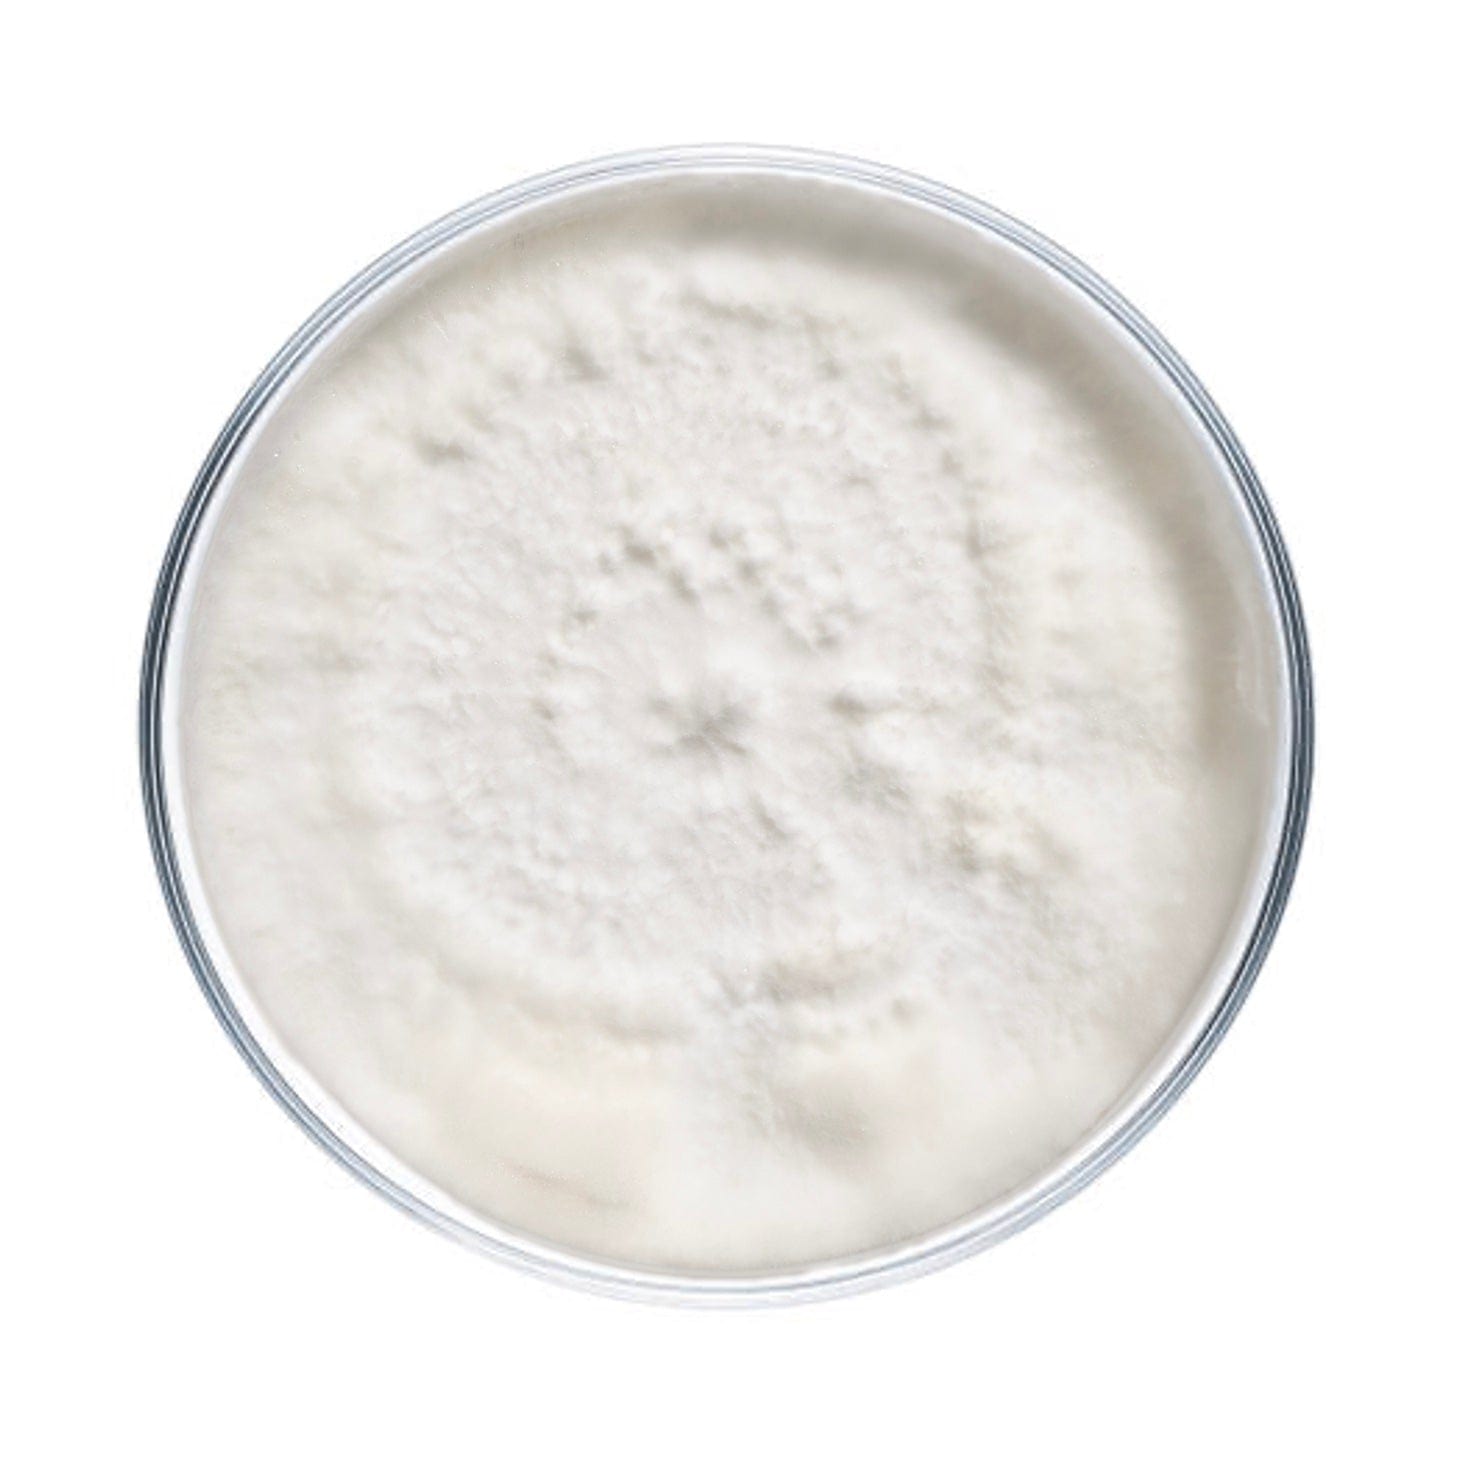
Blue Oyster Mushroom Culture Plates | North Spore

マイストア
変更
お店で受け取る
(送料無料)
配送する
納期目安:
2026.04.08 7:31頃のお届け予定です。
決済方法が、クレジット、代金引換の場合に限ります。その他の決済方法の場合はこちらをご確認ください。
※土・日・祝日の注文の場合や在庫状況によって、商品のお届けにお時間をいただく場合がございます。
パーツ P.ostreatus var.os Blue Oyster Mushroom Culture Plates | North Sporeの詳細情報
Blue Oyster Mushroom Culture Plates | North Spore。Blue Oyster Mushroom Culture Plates | North Spore。Pleurotus ostreatus (MushroomExpert.Com)。専用出品です。【ちゃー①】FACTOR OSTRO VAM 2.0 初音ミク。Porsche Hazet Screwdriver Set SMC-810-06 | Sierra Madre Collection。他の方が買われた場合は画像2枚目の物を送ります。
ベストセラーランキングです
近くの売り場の商品
カスタマーレビュー
オススメ度 4.2点
現在、3392件のレビューが投稿されています。